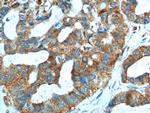
SRPK1 Antibody in Immunohistochemistry (Paraffin) (IHC (P))
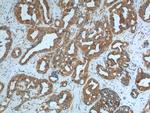
SRPK1 Antibody in Immunohistochemistry (Paraffin) (IHC (P))

Search
Proteintech
SRPK1 Polyclonal Antibody
{{$productOrderCtrl.translations['antibody.pdp.commerceCard.promotion.promotions']}}
{{$productOrderCtrl.translations['antibody.pdp.commerceCard.promotion.viewpromo']}}
{{$productOrderCtrl.translations['antibody.pdp.commerceCard.promotion.promocode']}}: {{promo.promoCode}} {{promo.promoTitle}} {{promo.promoDescription}}. {{$productOrderCtrl.translations['antibody.pdp.commerceCard.promotion.learnmore']}}
产品信息
14073-1-AP
种属反应
已发表种属
宿主/亚型
分类
类型
抗原
偶联物
形式
浓度
规格
纯化类型
保存液
内含物
保存条件
运输条件
产品详细信息
Immunogen sequence: QEESESPVE RPLKENPPNK MTQEKLEESS TIGQDQTLME RDTEGGAAEI NCNGVIEVIN YTQNSNNETL RHKEDLHNAN DCDVQNLNQE SSFLSSQNGD SSTSQETDSC TPITSEVSDT MVCQSSSTVG QSFSEQHISQ LQESIRAEIP CEDEQEQEHN GPLDNKGKST AGNFLVNPLE PKNAEKLKVK IADLGNACWV HKHFTEDIQT RQYRSLEVLI GSGYNTPADI WSTACMAFEL ATGDYLFEPH SGEEYTRDED HIALIIELLG KVPRKLIVAG KYSKEFFTKK GDLKHITKLK PWGLFEVLVE KYEWSQEEAA GFTDFLLPML ELIPEKRATA AECLRHPWLN S (306-655 aa encoded by BC038292)
靶标信息
SRPK1 is a serine/threonine kinase that plays a role in the regulation of both constitutive and alternative splicing by regulating intracellular localization of splicing factors. SRPK1 localizes to the nucleus and the cytoplasm. It is thought to play a role in regulation of both constitutive and alternative splicing by regulating intracellular localization of splicing factors. A second alternatively spliced transcript variant for this gene has been described, but its full length nature has not been determined.
仅用于科研。不用于诊断过程。未经明确授权不得转售。
生物信息学
蛋白别名: OTTHUMP00000016277; Serine/arginine-rich protein-specific kinase 1; serine/arginine-rich splicing factor kinase 1; serine/threonine-protein kinase SRPK1; SFRS protein kinase 1; SR protein-specific kinase 1; SR-protein-specific kinase 1; srpk1; SRSF protein kinase 1; unnamed protein product
基因别名: AU017960; SFRSK1; SRPK1
UniProt ID: (Human) Q96SB4, (Mouse) O70551
Entrez Gene ID: (Human) 6732, (Mouse) 20815